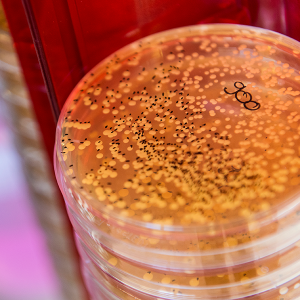

Ciências
Young Creators descobrem o Bio Hacking
Estas férias da Páscoa ficaram marcada pela participação dos Bugworkers, grupo

Estas férias da Páscoa ficaram marcada pela participação dos Bugworkers, grupo
Within the walls of Tec Labs there is a fully equipped

A Assembleia Geral das Nações Unidas declarou que 2015 será o

Decorreu ontem o lançamento oficial da iniciativa MARE STARTUP com a